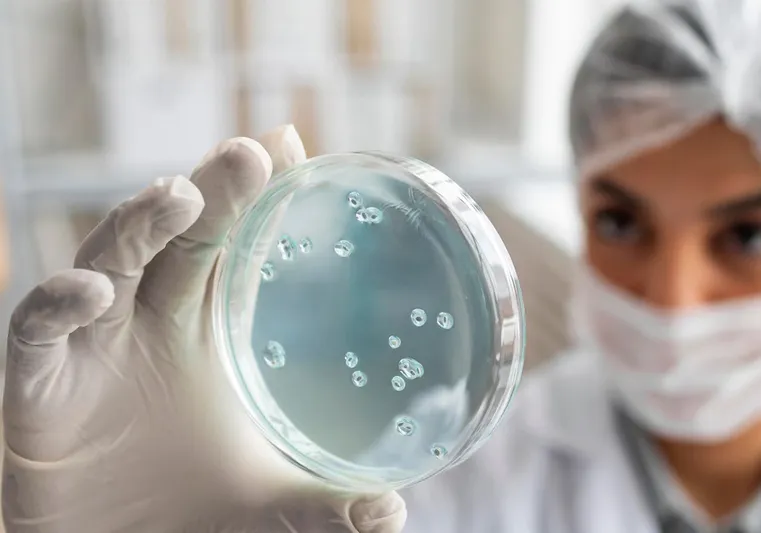
Infektológia

Hogyan zajlik egy infektológiai vizsgálat?
Anamnézis
Az infektológiai vizsgálatok a lehető legnagyobb óvintézkedések mentén zajlanak. Az első lépés minden esetben az anamnézis felállítása, aminek részeként a szakorvos türelmesen meghallgatja a páciens panaszait.
Mivel a szakorvosnak nagyon fontos megbizonyosodnia a lehetséges fertőzés körülményeiről, több kérdést is feltesz azzal kapcsolatban, hogy az illető hol járt, kikkel érintkezett az elmúlt hetekben, de az állatharapásokról, a rovarcsípésekről, sőt a szexuális együttlétekről is szükséges lehet információt gyűjteni bizonyos esetekben.
Fizikális vizsgálat
Amennyiben az infektológiára érkező páciens látható vagy tapintható tünetekkel érkezik, akkor a kezelőorvos a megfelelő óvintézkedések betartása mellett azokat is alaposan tanulmányozza.
A kiütéseket vagy egyéb bőrtüneteket szemügyre vételezéssel, a különféle gócokat vagy nyirokcsomó duzzanatokat pedig tapintással, miközben további kérdéseket tesz fel a páciens számára.
Laborvizsgálatok
Ha az infektológus megbizonyosodott róla, hogy a szakágához kapcsolódó betegség vagy fertőzés okozza a panaszokat, akkor egy alapos laborvizsgálat lesz a következő lépés.
A laboreredmények alapján ugyanis lehetőség van közelebb kerülni a probléma hátteréhez, de önmagában ez gyakran nem elegendő. Sok esetben mikrobiológiai és szerológiai vizsgálatok is kellenek, amelyek pontosan fel tudják tárni, hogy milyen kórokozók idézhették elő a fertőzést.
Kezelés
A diagnózis felállítását követően elkezdődhet a betegség kezelése. A legtöbbször gyógyszeres terápiára van szükség, de bőrtüneteknél előfordulhat, hogy külsőleg alkalmazható kenőcsöket is alkalmazni kell a mielőbbi gyógyuláshoz.
A leggyakoribb az antimikrobiális kezelés, amikor antibiotikummal próbálják visszaszorítani a fertőzést, de ez jellemzően a kapott diagnózis függvénye. A cél a rezisztens kórokozók kiiktatása a szervezetből, amihez ma már szerencsére számos gyógyszer áll a szakorvosok rendelkezésére.
A leggyakoribb betegségek az infektológián
Amint azt már fentebb többször is leírtuk, az infektológia nagyon összetett szakterület, ezért nehéz megemlíteni az összes olyan betegséget, amivel ez az ágazat foglalkozik.
Az alábbiakban ezért csak a leggyakoribb területeket, illetve az azokon belül található betegségeket említettük meg, amelyek segítenek abban, hogy jobban behatároljuk az infektológia feladatkörének határait.
Endémiás betegségek
Az endémiás betegségek a pandémiával ellentétben csak bizonyos területeken, kontinenseken, országokban vagy tájegységeken fordulnak elő, máshol azonban ritkábban vagy egyáltalán nem.
Tipikus endémiás problémák a trópusi betegségek, mint amilyen a malária, a hepatitisz, a Dengue-láz, a Leishmaniasis, a Chikungunya-láz vagy a Chagas-kór.
A közhiedelemmel ellentétben Magyarországon is vannak endémiás betegségek. Ilyen a Lyme-kór, a kullancscsípéssel terjedő agyvelőgyulladás, a leptoszpirózis, a nyúlpestis (tularémia), a hepatitisz egyes típusai vagy a szúnyogok által terjesztett betegségek.
Zoonózisok
A zoonózisok jellemzően az állatokhoz kapcsolódó fertőzések. Terjeszthetik rovarok, madarak, de emlősök is. A legismertebb hazánkban a Lyme-kór, de a nagyvilágból a madárinfluenza is ebbe a kategóriába sorolható.
Immunhiányos betegségek
A különféle immunhiányos betegségek diagnosztikája és kezelése egyaránt gyakran az infektológia feladata. Ide sorolható több autoimmun betegség, de az olyan gyenge immunrendszerrel rendelkező páciensek opportunista fertőzése is, mint a HIV.
Kórházi fertőzések
A legtöbb kórházi fertőzés kezelését szintén infektológus szakorvos látja el. Különösen fontos a szakág olyan esetekben, mint a nozokomiális infekciók, a húsevő baktériumok által okozott fertőzések vagy a vérfertőzés.
Mivel mindennek az alapja a higiénia, ezért az infektológia segítséget nyújthat, sőt iránymutatás adhat az egészségügyi intézményeknek a higiéniai protokollok kialakításában és a sterilizálásban, hogy a kérdéses fertőzések megelőzhetők legyenek.